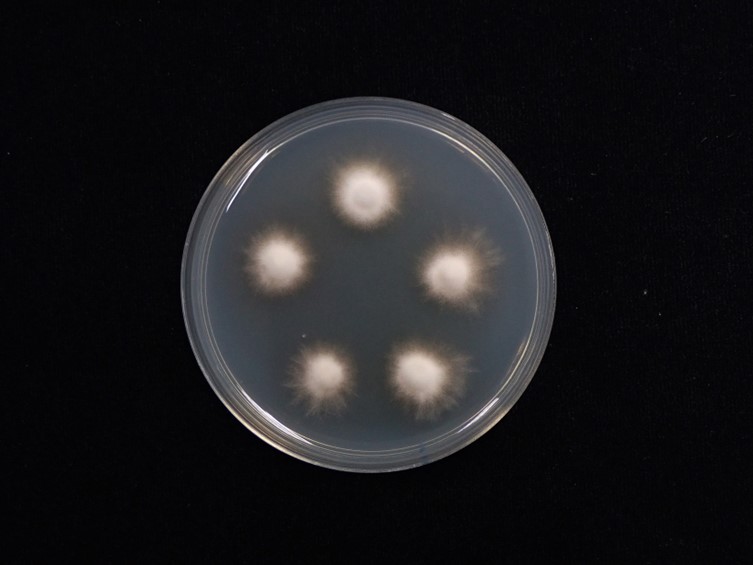

Holotype:
THAILAND, Nakhon Ratchasima Province, Khao Yai National Park, 23 Jul. 2009, K. Tasanathai, P. Srikitikulchai, S. Mongkolsamrit, R. Ridkaew, holotype BBH 29502, ex-type living culture BCC 37881.
Habitat:
Underside of dicotyledonous leaves.
Host:
Spiders (Araneae; Thomisidae; Diaea cf. dorsata).
Description:
 Host covered with greyish-brown mycelium.
Host covered with greyish-brown mycelium.  Perithecia growing in subiculum, aggregated in clusters, superficial, obpyriform, 850-1100 × 300-400 μm, ostiole pale brown.
Perithecia growing in subiculum, aggregated in clusters, superficial, obpyriform, 850-1100 × 300-400 μm, ostiole pale brown.  Asci cylindrical, 8-spored, 520-700 μm long, 4-6 μm broad, with cap 2-6 μm thick.
Asci cylindrical, 8-spored, 520-700 μm long, 4-6 μm broad, with cap 2-6 μm thick.  Ascospores hyaline, whole ascospores with septate part-spores alternately connected with thread-like structures, three-terminal cells on each end with six alternating pairs of cells and filament, eighteen cells per ascospore, up to 680 μm long, each cell narrowly fusiform, 10-20 × 1-2 μm, filiform regions, 30-50 × 0.2-0.8 μm.
Ascospores hyaline, whole ascospores with septate part-spores alternately connected with thread-like structures, three-terminal cells on each end with six alternating pairs of cells and filament, eighteen cells per ascospore, up to 680 μm long, each cell narrowly fusiform, 10-20 × 1-2 μm, filiform regions, 30-50 × 0.2-0.8 μm.  Asexual morph:
Asexual morph:  Synnema arising from the mycelial mat, numerous, greyish-brown, cylindrical to clavate, erect up to 800 μm long, 30-100 μm broad. Conidiogenous cells producing at the upper part of synnemata, mostly monophialidic or some polyphialidic.
Synnema arising from the mycelial mat, numerous, greyish-brown, cylindrical to clavate, erect up to 800 μm long, 30-100 μm broad. Conidiogenous cells producing at the upper part of synnemata, mostly monophialidic or some polyphialidic.  Phialides cylindrical, 7-16 × 2-5 μm, tapering into a distinct neck, 1-5 × 1-1.5 μm.
Phialides cylindrical, 7-16 × 2-5 μm, tapering into a distinct neck, 1-5 × 1-1.5 μm.  Conidia hyaline, fusiform, cylindrical, 3-12 × 1-3 μm.
Conidia hyaline, fusiform, cylindrical, 3-12 × 1-3 μm.
Culture characteristics:
Colonies on PDA attaining a diam of 8–10 mm in 21 d, cottony with high mycelium density in the middle of colonies, mycelium with low density around the margin of colonies, pale orange, reverse moderate orange, poor sporulation. Phialides arising from aerial hyphae, solitary, awl-shaped, lecanicillium-like, 10–35 × 1–2 μm. Conidia in the chains, hyaline, fusiform, cylindrical, smooth, 3–10 × 1.5–3 μm.
Colonies on PDA attaining a diam of 8–10 mm in 21 d, cottony with high mycelium density in the middle of colonies, mycelium with low density around the margin of colonies, pale orange, reverse moderate orange, poor sporulation. Phialides arising from aerial hyphae, solitary, awl-shaped, lecanicillium-like, 10–35 × 1–2 μm. Conidia in the chains, hyaline, fusiform, cylindrical, smooth, 3–10 × 1.5–3 μm.
Reference:
Mongkolsamrit S, Noisripoom W, Tasanathai K, et al. (2022). Comprehensive treatise of Hevansia and three new genera Jenniferia, Parahevansia and Polystromomyces on spiders in Cordycipitaceae from Thailand. MycoKeys 91: 113–149.
DOI: https://doi.org/10.3897/mycokeys.91.83091Species |
Strain |
Compound |
Pubchem CID |
Biological activity |
Reference |
|---|
|
Strain |
ITS | LSU | RPB1 | RPB2 | TEF1 |
|---|---|---|---|---|---|
| BCC 37881 | MZ684099 | MZ684010 | MZ707830 | MZ707843 | MZ707823 |
| BCC 37882 | MZ684100 | MZ684011 | MZ707831 | MZ707844 | MZ707824 |
| BCC 48932 | MZ684095 | MZ684012 | - | MZ707841 | MZ707819 |
| BCC 49257 | MZ684096 | MZ684013 | - | - | MZ707820 |
| BCC 54482 | MZ684097 | MZ684014 | - | - | MZ707821 |
| BCC 66224 | MZ684098 | MZ684015 | - | MZ707842 | MZ707822 |